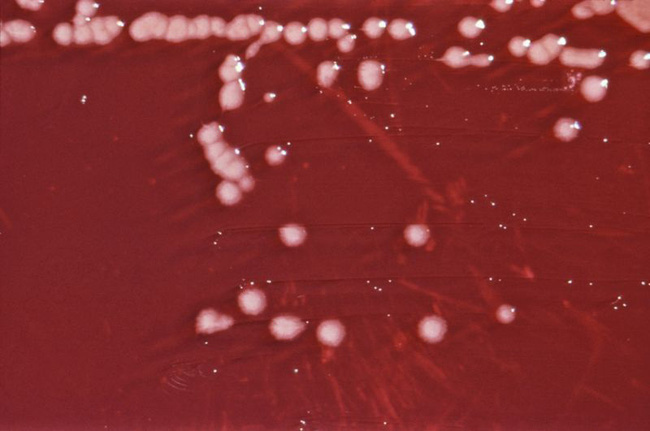
Khuẩn Pseudomonas

Nghe có vẻ khó tin nhưng sự thật là nếu bạn dí mũi vào ngửi chân của những chú cún nhà mình thì bên cạnh mùi hôi bạn còn có thể ngửi thấy một mùi hương quyến rũ đến bất ngờ, đó là mùi bỏng ngô.
Chính xác thì chân chó có mùi gần giống một loại snack ngô của nước ngoài - Fritos. Thậm chí, người ta còn đặt cho nó một cái tên riêng là "Frito Feet" (chân Frito, hoặc chân bỏng ngô).

Không tin ư, bạn hãy thử với cún cưng nhà mình ngay để chứng thực nhé. Nhưng tại sao chân chó lại có mùi kỳ lạ này nhỉ?
Ở các loài động vật (bao gồm cả con người), da là bộ phận chứa rất nhiều vi khuẩn. Có đến hàng nghìn tỉ con vi khuẩn, với mật độ lên tới hàng trăm ngàn trên mỗi centimet vuông trên da của con người.
Đối với loài chó, số lượng và mật độ vi khuẩn trên da chúng chỉ có hơn chứ không thể kém so với con người. Đặc biệt ở khu vực bàn chân chó, đây là nơi vi khuẩn phát triển với tốc độ chóng mặt vì có đủ những điều kiện lý tưởng như: độ ẩm cao, lưu thông khí thấp, thân nhiệt hoàn hảo (khoảng 38 - 39 độ C).
Khuẩn Pseudomonas.
Khuẩn Pseudomonas.
Trong quá trình sinh sôi, các vi sinh vật sẽ thải ra các loại khí với những mùi hương đặc trưng riêng. Trong số đó, có một số vi khuẩn nổi bật với những mùi hương quyến rũ như Proteus với mùi ngọt như siro ngô hoặc khuẩn Pseudomonas có mùi giống hoa quả, nhưng thường gần giống với mùi bắp rang bơ hơn. Chúng chính là nguyên nhân khiến chân chó có mùi kỳ lạ đấy.
 AI
AI
 Hướng dẫn AI
Hướng dẫn AI
 ChatGPT
ChatGPT
 Gemini
Gemini
 Thư viện Prompt
Thư viện Prompt
 Công nghệ
Công nghệ
 Học IT
Học IT
 Tiện ích
Tiện ích









 Hướng dẫn AI
Hướng dẫn AI
 Ứng dụng
Ứng dụng
 Hệ thống
Hệ thống
 Game - Trò chơi
Game - Trò chơi
 iPhone
iPhone
 Android
Android
 Làng Công nghệ
Làng Công nghệ
 Hàm Excel
Hàm Excel
 Cuộc sống
Cuộc sống
 Khoa học
Khoa học
